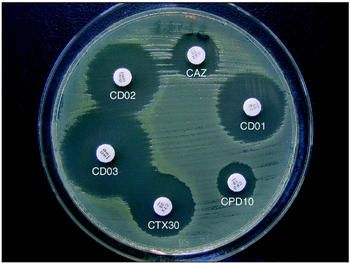
Antibiograma.jpg

Página 54 de 80
Re: Fotos de análisis Coprológicos de nuestas aves.
Publicado: Vie Nov 08, 2013 11:02 pm
por salobreña
ivan_peska escribió:Hola
Puede ser que en esta imagen haya una levadura
Otra cosa, alguien me podría decir algún software que este bien pa la cámara de mi micro
un saludo
Hola Ivan, en cuato a lo que comentas de la otra camara, el Pedro es experto en la materia, pero si tu ordenata no admite cds mal asunto.
En cuanto a tu pregunta si es posible que sea una gemacion de levaduras pero no se ve con claridad, no has enfocado bien la camara.
imagino que tienes los oculares graduados para tu vista, pero eso no significa que esten graduados para la camara.....en primera instancia tienes que sujetar la camara con una mano, y con la otra tienes que enfocar con el micrometrico a traves de la pantalla de la camara, y una ves enfocado entonces puedes disparar......saludos
PD: vaya, par de manojos de critales que te han salido en la foto!!.
Re: Fotos de análisis Coprológicos de nuestas aves.
Publicado: Dom Nov 10, 2013 7:27 pm
por coroneldelinares2
bueno aqui os dejo una muestra de un pajaro moribundo de captura de ayer...estoy intentando enderezarlo y por lo menos e conseguio que vaya a mejor espero salvarlo... no se si con las fotos se podran distinguir bacterias pero creo que las hay y se mueven bastante... esperaba escontrar algun coccidio y verlo claramente y distinguirlo pero nunca e visto uno en directo no se si se veran en lo que pongo(creo que no lo son) o se trata de otra cosa... me gustaria una explicacion basica y diferencia al ojjo de bacterias gram positivas y gram negativas. un saludo
Re: Fotos de análisis Coprológicos de nuestas aves.
Publicado: Dom Nov 10, 2013 9:51 pm
por salobreña
coroneldelinares2 escribió:bueno aqui os dejo una muestra de un pajaro moribundo de captura de ayer...estoy intentando enderezarlo y por lo menos e conseguio que vaya a mejor espero salvarlo... no se si con las fotos se podran distinguir bacterias pero creo que las hay y se mueven bastante... esperaba escontrar algun coccidio y verlo claramente y distinguirlo pero nunca e visto uno en directo no se si se veran en lo que pongo(creo que no lo son) o se trata de otra cosa... me gustaria una explicacion basica y diferencia al ojjo de bacterias gram positivas y gram negativas. un saludo
Hola Juan
No se ve nata extraño en esa muestra, las figuras redondas son critales de urea......en este tipo de muestras es imposible distinguir las bacterias Gram + de la Gram -, y ademas tampoco valdria de nada, saber que son de una o de otra.......positivo o negativo, no es relevante solo se trata de que unas bacterias tienen una capacidad para retener un colorante y otras no, sin que ello signifique mas, hay bacterias Gram + que son inofensivas y otras que no lo son, y de las Gram - iden de iden.
Ya te comente que en este tipo de muestras se mueve casi todo, por la propia flotabilidad de la muestra, y a veces las particulas muy pequeñas se mueven de una manera casi orbital con pequeños mivimientos de traslacion vibrante.
Si quieres ver bacilos en movimiento, conserva una muestra un par de dias en un vial, y a las 48 horas o mas la observas y veras a las bacterias que se desplazan por el fondo.((La muestra guardada ha de estar siempre humeda)).......saludos
PD: Si es un pajaro recien capturado, es posible que se este resistiendo a alimentarse, o se esta desidratando, pero si realmente esta enfermo, las probabilidades mas altas son la coccidiosis.
Atibiograma
Publicado: Dom Nov 10, 2013 10:07 pm
por salobreña
Hola
Os dejo una foto de una prueba de antibiograma......a veces cuando los especialistas se encuentran con una bacteria mas resistente de lo habitual, o una nueva cepa rebelde, han de hacer pruebas para buscar el antibiotico mas efectivo......se trata de un trabajo sencillo pero de laboratorio especializado, primero hay que aislar el agente y cultivarlo en un medio favorable, y luego se le aplica a este medio, discos u otras formas impregnadas en diferentes antibioticos.......cuanto mas efectivo sea un antibiotico para una bacteria, menos se acercara esta a tal antibiotico, por lo tando y visto en la foto representa que, cuanto mayor sea el halo creado, mayor es su eficacia para dicha bacteria, y por lo tanto seria el antibiotico de eleccion para tratarla........saludos
PD: En el caso de la foto el antibiotico elegido seria el CD03.
- Antibiograma.jpg (41.83 KiB) Visto 2212 veces
Re: Fotos de análisis Coprológicos de nuestas aves.
Publicado: Dom Nov 10, 2013 10:09 pm
por coroneldelinares2
Gracias por la respuesta manuel. Es que veo en.las muetras unos movimirntos de estas esferas pequeñas.y que se envuentran en el fondo como si fueran movimiento propio osea que parece que no se debe al flujo de la muestra por eso decia que podian ser bacterias. Te doy la razon en lo de la alimentacion y es muy probable. Un saludo
[ Post made via Android ] 
Re: Fotos de análisis Coprológicos de nuestas aves.
Publicado: Dom Nov 10, 2013 10:17 pm
por salobreña
coroneldelinares2 escribió:Gracias por la respuesta manuel. Es que veo en.las muetras unos movimirntos de estas esferas pequeñas.y que se envuentran en el fondo como si fueran movimiento propio osea que parece que no se debe al flujo de la muestra por eso decia que podian ser bacterias. Te doy la razon en lo de la alimentacion y es muy probable. Un saludo
[ Post made via Android ] 
Juan intenta alimentarlo con papilla de embuchar jeringa y aguja.......con cuidado porque forzar a un adulto se corren muchos riesgos, hay que cercirarse con el tacto de que la aguja esta dentro del buche, porque si no se puese afixiar en segundos, y si no pues plan B, ya lo sabes......saludos
Re: Fotos de análisis Coprológicos de nuestas aves.
Publicado: Dom Nov 10, 2013 10:52 pm
por coroneldelinares2
Manuel esta saliendo adelante...y la verda no esperaba que aguantara la noche...pero le meti un bioserine y le puse una bombillita cerca para que le diera calor y a ala vez ganas dd beber... Hoy ya no se ha embolao y va comiendo sobre to la pasta de cria.n. Si mañana veo que no come suficiente le metere un jeringazo pero creo que no ara falta ya comejtare como va...y si le cuesta adaptarse pues a volar pero no quiero soltarlo sin fuerza porque no durara na. Un saludo compañeroo
[ Post made via Android ] 
Re: Fotos de análisis Coprológicos de nuestas aves.
Publicado: Lun Nov 11, 2013 10:35 pm
por salobreña
Hola
Sin novedad en el cuartel, por lo tanto os pongo fotos de mas de lo mismo......las tres fotos es practicamente lo mismo, son fotos de urea, pero algunas con luz polarizada.
Para polarizar la luz uso el displey partido en dos de una calculadora vieja uno de los trozos lo situo entre los oculares y los objetivos, y el otro entre el foco de luz del micro y la muestra, y este ultimo es el que giro para los distintos grados de polarizacion......saludos

- TS_11_06_14_52_19.JPG (145.96 KiB) Visto 2197 veces

- TS_11_06_14_51_43.JPG (159.7 KiB) Visto 2197 veces

- TS_11_06_14_50_47.JPG (155.49 KiB) Visto 2197 veces
Re: Fotos de análisis Coprológicos de nuestas aves.
Publicado: Mar Nov 12, 2013 8:17 pm
por Pedro J
Hola
Se trata esto de una especie de hongo
y una foto de bacterias muy oscura

Re: Fotos de análisis Coprológicos de nuestas aves.
Publicado: Mar Nov 12, 2013 8:50 pm
por salobreña
Hola Pedro
En la primera foto si da la impresion de que se trate de un hongo, pero falta definicion para asegurarlo, la segunda me parece claramente una estructura vegetal.......si te queda muestra de eso haz una tincion a ver si sale alguno......si tiñe de positivo casi seguro que es un hongo, si tiñe de otro color falsa alarma.......saludos
Re: Fotos de análisis Coprológicos de nuestas aves.
Publicado: Mié Nov 13, 2013 4:53 pm
por Pedro J
Hola Manuel ya no tengo la muestra pero yo tan bien coincidi en que la primera foto fuera un hongo
[ Post made via Android ] 
Re: Fotos de análisis Coprológicos de nuestas aves.
Publicado: Mié Nov 13, 2013 7:09 pm
por salobreña
Pedro J escribió:Hola Manuel ya no tengo la muestra pero yo tan bien coincidi en que la primera foto fuera un hongo
[ Post made via Android ] 
Ya!! Pedro, pero es que ese color verdoso que tiene, me hace dudar mucho.......los hongos no tienen buena relacion con la luz, y no fabrican clorofila, por lo tanto nunca son verdes, por lo menos a vista de microscopio, aunque a vista simple y directa, algun moho pueda parecerlo......saludos
Re: Fotos de análisis Coprológicos de nuestas aves.
Publicado: Mié Nov 13, 2013 7:58 pm
por ivan_peska
Hola manuel
Sobre las bacterias gram + y gram - buenas y malas. Mi pregunta es si tienen la misma forma o son diferentes y si hay alguna manera de diferenciar si las bacterias gram + o gram - son buenas o malas.
un saludo
Re: Fotos de análisis Coprológicos de nuestas aves.
Publicado: Vie Nov 15, 2013 11:39 pm
por salobreña
ivan_peska escribió:Hola manuel
Sobre las bacterias gram + y gram - buenas y malas. Mi pregunta es si tienen la misma forma o son diferentes y si hay alguna manera de diferenciar si las bacterias gram + o gram - son buenas o malas.
un saludo
Hola
Ivan, con un micro optico, eso no es posibe, o si, pero antes habria que hacer un monton de pruebas, que no estan a nuestro alcance, son cosas de labaratorio.......lo especialistas en microbiologia, solo con ver como y de que forma crecen las colonias de una bacteria aislada y en un cultivo, son capaces de saber a que familia o especie pertenece tal o cual bacteria, pero par concretar una especimen concreto hay que hacer varias pruebas de laboratorio.......saludos
Re: Fotos de análisis Coprológicos de nuestas aves.
Publicado: Sab Nov 16, 2013 4:36 pm
por salobreña
Hola
La casualidad ha querido que me tope con algo parecido a lo que expuso Pedro el otro dia.....evidentemente no parece lo mismo ya que lo que puso Pedro era a mi parecer bastante mas grande, pero es algo parecido.
En este caso he podido comprobar que se trata de cristales, y posiblemente de los minerales que portan un nuevo protector hepatico((nuevo par mi,claro esta)) que estoy probando.....saludos

- TS_11_15_13_30_57.JPG (20.24 KiB) Visto 2298 veces

- TS_11_15_13_20_34.JPG (21.01 KiB) Visto 2298 veces